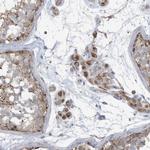
GTPBP2 Antibody in Immunohistochemistry (IHC)

Search
Invitrogen
GTPBP2 Polyclonal Antibody
{{$productOrderCtrl.translations['antibody.pdp.commerceCard.promotion.promotions']}}
{{$productOrderCtrl.translations['antibody.pdp.commerceCard.promotion.viewpromo']}}
{{$productOrderCtrl.translations['antibody.pdp.commerceCard.promotion.promocode']}}: {{promo.promoCode}} {{promo.promoTitle}} {{promo.promoDescription}}. {{$productOrderCtrl.translations['antibody.pdp.commerceCard.promotion.learnmore']}}
产品信息
PA5-56738
种属反应
宿主/亚型
分类
类型
抗原
偶联物
形式
浓度
规格
纯化类型
保存液
内含物
保存条件
运输条件
RRID
产品详细信息
Immunogen sequence: DGNIEYKLKL VNPSQYRFEH LVTQMKWRLQ EGRGEAVYQI GVEDNGLLVG LAEEEMRASL KTLHRMAEKV GADITVLRER EVDYDSDMPR KITEVLVRKV P
Highest antigen sequence identity to the following orthologs: Mouse - 99%, Rat - 100%.
靶标信息
Small G proteins act as molecular switches for regulation of variety of cellular processes, such as nuclear transport, signal transduction, membrane trafficking and protein synthesis. GTPBP2 (GTP-binding protein 2) is a 602 amino acid G protein that is expressed in kidney, skeletal muscle, testis, brain and thymus, though it is not detected in liver. Expression of GTPBP2 is enhanced by ©-interferon stimulation in HeLa cells, THP-1 cells and thioglycollate-elicited mouse peritoneal macrophages. There are four isoforms of GTPBP2 that are expressed as a result of alternative splicing events. Since mutation of the gene encoding GTPBP1 does not lead to any phenotypic abnormalities, it is thought that there may be a genetic redundancy to make up for GTPBP1 lack-of-function. GTPBP2 shares 44% sequence similarity with GTPBP1 and also overlaps in expression pattern, suggesting that the GTPBP2 gene may compensate for GTPBP1 genetic abnormalities.
仅用于科研。不用于诊断过程。未经明确授权不得转售。
生物信息学
蛋白别名: GTP-binding protein 2; GTPBP2; unnamed protein product
基因别名: GTPBP2; JABELS
UniProt ID: (Human) Q9BX10
Entrez Gene ID: (Human) 54676